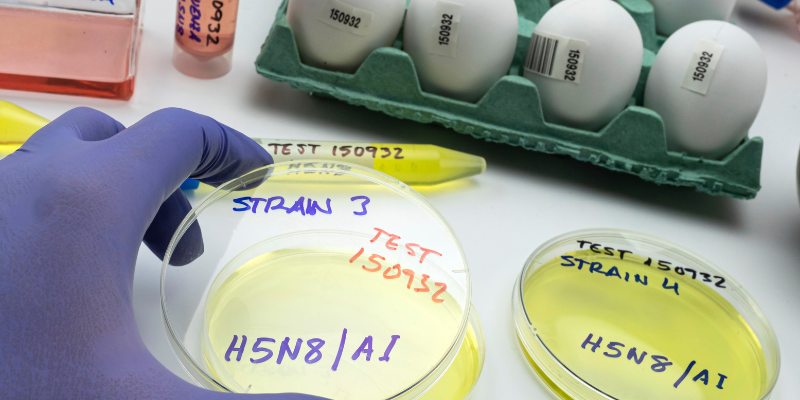
Where did bird flu go?

We’re all thinking the same thing, but no one wants to jinx it…where did bird flu go?
Its absence here in the UK is conspicuous but certainly welcome. The avian influenza ‘year’ begins in October and so far, we’ve had just 5 cases.
Last year our phones seemed to buzz non-stop with notifications of new infections, so the contrast is startling. We thought 'Flockdown' would be a big part of our Autumn/Winter plans, but it didn't happen. Now we're all confused.
We’re not the only ones. Avian scientists and the commercial cull teams are a bit bewildered too. Europe is similarly quiet but sadly the US, is now being subjected to similar incidents that we experienced a year ago.
The unseasonably warm start to the Autumn across the northern hemisphere caused a late migration. We believed that as soon as the birds arrived, the flu would also arrive. Fortunately, we were wrong and a fascinating lecture at APHA at Weybridge in October, shed some light on why this might be the case. Here are the key points:
Nature's twists and turns
It is common knowledge that wild birds are the most widespread vector of the disease. Interestingly, the 5 breeds of wild birds most commonly affected in 2021/22 were different from the 5 in 2022/23. Not just a bit, they were COMPLETELY different and it came as a bit of a surprise to us all.
Life finds a way
Biologists tested many of the survivors in highly affected flocks from the earlier season and discovered something incredible. These birds had naturally developed antibodies to highly pathological Avian Influenza. We all remember Jeff Goldblum in Jurassic Park, muttering the immortal words ‘Life finds a way’, it seems he was right!
Bird Flu transmission
To the best of my knowledge, there is a lack of clarity regarding the transmission of immunity to chicks. Do they also have these antibodies? Were they born with them (transovarian)? Can they develop them through parental contact?
Don’t forget that most species of chicks are ‘precocial’ and are fed by their parents. Could antibodies be transferred through saliva, especially when food is regurgitated? It’s a well-known fact that mammals can transfer antibodies through their milk while suckling their young, so could birds have an equivalent?

Vaccine, Vaccine, Vaccine
Where does vaccination fit into all this? Is vaccination helping?
China has been using billions of doses of bird flu vaccines for several years now. Avian Influenza originated in the region and in the early days it caused hundreds of fatal cases in humans. Given that they were potentially facing an epidemic of mass proportions, they had little choice.
To protect against current strains, they need to administer a raft of different vaccines. It’s time-consuming and expensive but absolutely worth the effort.
What about vaccination in Europe and the US? We would need billions of doses to cover all the broiler, layer and pet chickens across the two regions. Who would make the vaccines? Who would administer them? Who is paying for all of this? Given that birds are not tagged with identifiers, and they are the most numerous farmed animals on the planet, working out who is vaccinated and who isn’t would be a nightmare! Frustratingly, chickens who are vaccinated may still become infected with bird flu but would be asymptomatic.
It’s not unlike the issue we had with COVID vaccines. If governments decided to ‘roll out’ a vaccination program, they would need vets to regularly test flocks to check for hidden infections.
France calculated that if they vaccinated all their poultry, they would need 350 full-time vets JUST to carry out the surveillance. Earlier this year France took the decision to vaccinate their ducks.
For those of you who are not aware, Avian Influenza spreads like wildfire through commercial duck populations. The US is not prepared to import vaccinated livestock with the associated risks, and this has seriously affected the market for this vital export. The difficulties surrounding mass vaccination mean it is unlikely we’ll see any poultry receiving a vaccine any time soon.

Experts Advice
The advice from the experts remains the same. The greatest weapon in the fight against bird flu is good biosecurity. Maintaining high standards in commercial settings where birds are housed is certainly easier than free-range back garden ones. So, what can you do to keep you and your flock safe?
Deter wild birds, don’t let your flock drink from ponds or puddles (known as ‘virus soup’ amongst vets), and never, ever, kiss a seagull!
Our 2m Run is ideal for providing a secure outdoor space, and can be extended as far as you like in additional 1m sections.